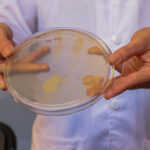
Unnamed (6)

Anuncia inversión Ventagium en Querétaro
El titular de la Secretaría de Desarrollo Sustentable (SEDESU), Marco Antonio Del Prete Tercero, encabezó el anuncio de inversión de Ventagium Data Consulting, empresa dedicada al desarrollo de software para inteligencia artificial y analíticos avanzados, así como servicios para cadenas de suministro, marketing, logística y ONGs, con lo cual se generarán 120 empleos.
Durante su intervención, Marco Del Prete indicó que desde la administración estatal se cumple con la tarea de impulsar a las pequeñas y medianas empresas como el caso de Ventagium, la cual, por el sector al que atiende, es amigable con el medio ambiente.
“Celebramos mucho que haya más emprendimiento, que se estén instalando empresas, que se estén generando empleos, que hay retos para conseguir empleo es evidente, nosotros también lo vivimos, pero vamos de la mano, somos equipo, cuenten con la Secretaría de Desarrollo Sustentable y con el ecosistema triple hélice que hemos desarrollado en Querétaro para alcanzar los objetivos de Ventagium”, señaló.
El titular de SEDESU informó que se continuará con el impulso de proyectos que generen valor, que agreguen talento y que requieran competencias adicionales, ya que eso es lo que hace diferente a Querétaro de otras regiones, que aquí se apuesta a la competitividad, al crecimiento a través del conocimiento y desde del cuidado del medio ambiente.
Finalmente informó que desde la SEDESU y a través del Programa Estatal para el Desarrollo de Tecnología e Innovación (PEDETI), se promueve la adopción de nuevas tecnologías en Micro, Pequeñas y Medianas Empresas (MiPyMEs) para incrementar su productividad; en 2022 se apoyaron 41 proyectos, con un monto superior a los 17 millones de pesos y para 2023, se beneficiaron a 46 con más de 18 millones de pesos.
En su participación, el CEO y Fundador de Ventagium Data Consulting, Arturo Torres Arpi Acero, aseguró que es gracias a todos los pilares con los que se han encontrado al emprender que pueden seguir apostando por desarrollar el talento mexicano y de esta manera hacer que este mundo mejore.

Comentar con Facebook